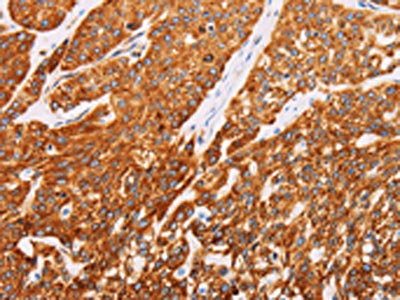

SYVN1 Antibody
-
中文名稱:SYVN1兔多克隆抗體
-
貨號(hào):CSB-PA831487
-
規(guī)格:¥1100
-
圖片:
-
The image on the left is immunohistochemistry of paraffin-embedded Human thyroid cancer tissue using CSB-PA831487(SYVN1 Antibody) at dilution 1/10, on the right is treated with fusion protein. (Original magnification: ×200)
-
The image on the left is immunohistochemistry of paraffin-embedded Human esophagus cancer tissue using CSB-PA831487(SYVN1 Antibody) at dilution 1/10, on the right is treated with fusion protein. (Original magnification: ×200)
-
Gel: 8%SDS-PAGE, Lysate: 40 μg, Lane 1-3: Lovo cells, hela cells, 293T cells, Primary antibody: CSB-PA831487(SYVN1 Antibody) at dilution 1/100, Secondary antibody: Goat anti rabbit IgG at 1/8000 dilution, Exposure time: 1 minute
-
-
其他:
產(chǎn)品詳情
-
Uniprot No.:
-
基因名:
-
別名:SYVN1; HRD1; KIAA1810; E3 ubiquitin-protein ligase synoviolin; RING-type E3 ubiquitin transferase synoviolin; Synovial apoptosis inhibitor 1
-
宿主:Rabbit
-
反應(yīng)種屬:Human,Mouse
-
免疫原:Fusion protein of Human SYVN1
-
免疫原種屬:Homo sapiens (Human)
-
標(biāo)記方式:Non-conjugated
-
抗體亞型:IgG
-
純化方式:Antigen affinity purification
-
濃度:It differs from different batches. Please contact us to confirm it.
-
保存緩沖液:-20°C, pH7.4 PBS, 0.05% NaN3, 40% Glycerol
-
產(chǎn)品提供形式:Liquid
-
應(yīng)用范圍:ELISA,WB,IHC
-
推薦稀釋比:
Application Recommended Dilution ELISA 1:1000-1:2000 WB 1:200-1:1000 IHC 1:25-1:100 -
Protocols:
-
儲(chǔ)存條件:Upon receipt, store at -20°C or -80°C. Avoid repeated freeze.
-
貨期:Basically, we can dispatch the products out in 1-3 working days after receiving your orders. Delivery time maybe differs from different purchasing way or location, please kindly consult your local distributors for specific delivery time.
-
用途:For Research Use Only. Not for use in diagnostic or therapeutic procedures.
相關(guān)產(chǎn)品
靶點(diǎn)詳情
-
功能:E3 ubiquitin-protein ligase which accepts ubiquitin specifically from endoplasmic reticulum-associated UBC7 E2 ligase and transfers it to substrates, promoting their degradation. Component of the endoplasmic reticulum quality control (ERQC) system also called ER-associated degradation (ERAD) involved in ubiquitin-dependent degradation of misfolded endoplasmic reticulum proteins. Also promotes the degradation of normal but naturally short-lived proteins such as SGK. Protects cells from ER stress-induced apoptosis. Protects neurons from apoptosis induced by polyglutamine-expanded huntingtin (HTT) or unfolded GPR37 by promoting their degradation. Sequesters p53/TP53 in the cytoplasm and promotes its degradation, thereby negatively regulating its biological function in transcription, cell cycle regulation and apoptosis. Mediates the ubiquitination and subsequent degradation of cytoplasmic NFE2L1. During the early stage of B cell development, required for degradation of the pre-B cell receptor (pre-BCR) complex, hence supporting further differentiation into mature B cells.
-
基因功能參考文獻(xiàn):
- This study showed that Herp stability was regulated by synoviolin through lysine ubiquitination-independent proteasomal degradation. PMID: 29863080
- Hrd1 is an E3 ubiquitin ligase in human T cells.IHrd1 expression is increased in CD4-positive T cells from multiple sclerosis patients. PMID: 27417417
- PADI4 interacted with SYVN1 directly and that overexpression of PADI4 suppressed the ubiquitination of proteins. Thus, a reduction in ER stress induced by PADI4 may abrogate the initiation of chronic RA by suppressing the proliferative signals of RA synoviocytes. PMID: 29039504
- Amyloid beta oligomers modulate BACE1 through an XBP-1-dependent pathway involving HRD1. PMID: 27853315
- findings support a model of Hrd1 complex formation, where the Hrd1 cytoplasmic domain and FAM8A1 have a central role in the assembly and activity of this ERAD machinery. PMID: 28827405
- HSP70-Hrd1 axis represents a potential therapeutic target for restoring the oncorepressor activity of unstable lymphoma-associated Blimp-1 mutants. PMID: 28842558
- this study proved that SYVN1 enhances SERPINA1(E342K)/ATZ degradation through SQSTM1-dependent autophagy and attenuates SERPINA1(E342K)/ATZ cytotoxicity. PMID: 28121484
- Results demonstrated that overexpression of Hrd1 increased the proteasomal degradation and microtubule-dependent aggresome formation of OPTN in the microtubular organizing center, whereas knockdown of Hrd1 stabilized OPTN and inhibited aggresome formation of OPTN. PMID: 28334804
- Data show that E3 ubiquitin ligase HRD1 (HRD1) decreased the protein level of S100A8 through ubiquitination. PMID: 28423597
- Analysis of affinity-captured Hrd1 complexes from these cells by size-exclusion chromatography, immunodepletion, and absolute quantification mass spectrometry identified two major high-molecular-mass complexes with distinct sets of interacting proteins and variable stoichiometries, suggesting a hitherto unrecognized heterogeneity in the functional units of Hrd1-mediated protein degradation. PMID: 28411238
- This study provides new knowledge of the CFTR biosynthetic pathway. It suggests that SYVN1 and FBXO2 represent two distinct multiprotein complexes that may degrade DeltaF508-CFTR in airway epithelia and identifies a new role for NEDD8 in regulating DeltaF508-CFTR ubiquitination. PMID: 27756846
- Study shows that mir125b is up-regulated in osteoarthritis (OA) and inversely correlated with SYNV1 expression. Also, findings demonstrated that miR- 125b-5p could promote apoptosis of synovial cells through targeting the SYVN1 gene, and the excessive apoptosis of synovial cells could contribute to the development of OA. PMID: 28260078
- HRD1 is a novel substrate for USP19. USP19 negatively regulates the ubiquitination of HRD1 and prevents it from undergoing proteasomal degradation. PMID: 27827840
- Prion protein mutants inhibit Hrd1-mediated retrotranslocation of misfolded proteins by depleting misfolded protein sensor BiP. PMID: 26740554
- OS-9, an ER-resident lectin, acts downstream of Grp94 to further recognize misfolded alpha1 subunits in a glycan-dependent manner. This delivers misfolded alpha1 subunits to the Hrd1-mediated ubiquitination and the valosin-containing protein-mediated extraction pathway. PMID: 26945068
- These findings uncover a novel role for HRD1 in breast cancer. PMID: 26536657
- The inherently unstable nature of the human SEL1L protein lies in its transmembrane domain, and that association of HRD1 with the SEL1L transmembrane domain restored its stability. PMID: 26471130
- specific silencing of Derlin-2, p97 and HRD1 by shRNAs increases steady state levels of proinsulin. these ERAD constituents are critically involved in proinsulin degradation and may therefore also play a role in subsequent antigen generation. PMID: 26107514
- Charcot-Marie-Tooth disease-related PMP22 is trapped in the endoplasmic reticulum by calnexin-dependent retention and Rer1-mediated early Golgi retrieval systems and partly degraded by the Hrd1-mediated endoplasmic reticulum-associated degradation system. PMID: 25385046
- Results show that HRD1 and RFP2 contributes are required for the disposal of V247M alpha-sarcoglycan mutant. PMID: 24565866
- Herp localizes to the endoplasmic reticulum-derived quality control compartment (ERQC) and recruits HRD1, which targets to endoplasmic reticulum associated degradation the substrate presented by the OS-9 lectin at the ERQC. PMID: 24478453
- identified Hrd1 as a novel E3 ubiquitin ligase responsible for compromised Nrf2 response during liver cirrhosis PMID: 24636985
- a new HRD1-associated membrane protein named HERP2, which is homologous to the previously identified HRD1 partner HERP1. Despite sequence homology, HERP2 is constitutively expressed in cells, whereas HERP1 is highly induced by ER stress. PMID: 24366871
- the interactions between P97 and these motifs, including VCP-binding motif (VBM) and VCP-interacting motif (VIM). The solution structures of the VBM motif from HRD1 and the VIM motif from SVIP are both comprised mainly of a single alpha-helix. PMID: 24100225
- derlin2 functions with HRD1 in ERAD of certain substrates independent of their glycosylation status. PMID: 23867461
- subset of integral membrane proteins, therefore, requires an early dislocation event to expose part of their luminal domain to the cytosol, before HRD1-mediated polyubiquitination and dislocation PMID: 23929775
- Synoviolin up-regulates amyloid beta production by targeting a negative regulator of gamma-secretase, Rer1, for degradation. PMID: 23129766
- Hrd1 functions as an E3 targeting tau or abnormal p-tau for proteasome degradation. PMID: 22280354
- regulation of the stability and assembly of the HRD1-SEL1L complex is critical to optimize the degradation kinetics of ERAD substrates PMID: 21454652
- binding of Herp to Hrd1-containing ERAD complexes positively regulates the ubiquitylation activity of these complexes, thus permitting survival of the cell during ER stress. PMID: 21149444
- data support a physiological role for HRD1 and UBE2J1 in the homeostatic regulation of MHC class I assembly and expression PMID: 21245296
- Using brain tissue from Alzheimer's disease and normal subjects, a negative correlation was found between the expressed levels of HRD1 and of amyloid-beta; this suggests the possible involvement of HRD1 in amyloid-beta generation. PMID: 20606367
- serine-dependent, HRD1-mediated ubiquitination targets TCRalpha to the ERAD pathway PMID: 20519503
- HRD1 promotes ubiquitination and degradation of amyloid precursor protein (APP) that leads to decreased amyloid beta production, whereas HRD1 loss in Alzheimer's disease leads to accumulation of APP and increased levels of amyloid beta. PMID: 20237263
- These data demonstrate a role of the E3 ubiquitin ligases in CTA1 retro-translocation. PMID: 19864457
- The results support that gp78 is an E3 targeting CFTRDeltaF508 for degradation and Hrd1 inhibits CFTRDeltaF508 degradation by acting as an E3 for gp78. PMID: 19828134
- HRD1 protects against endoplasmic reticulum stress-induced apoptosis through endoplasmic reticulum-associated degradation. PMID: 12459480
- endogenous hHrd1 resides in the ER and has a ubiquitin-ligase activity PMID: 12646171
- Human HRD1 is an E3 ubiquitin ligase involved in degradation of proteins from the endoplasmic reticulum PMID: 14593114
- Results showed that Synoviolin, a novel causative factor for rheumatoid arthritis, is up-regulated in proliferating synovial cells in the disease. PMID: 16786162
- Elevated peripheral blood (PB) levels of synoviolin were associated with nonresponse to infliximab treatment. Upregulation of synoviolin by IL-lbeta and TNFalpha may contribute to prolonged survival of immune cells and rheumatoid arthritis chronicity. PMID: 16802346
- These results suggest that Hrd1 is a novel htt-interacting protein that can target pathogenic httN for degradation and is able to protect cells against httN-induced cell death. PMID: 17141218
- the endoplasmic reticulum-resident ubiquitin ligase 'Synoviolin' destroys p53 PMID: 17170702
- endoplasmic reticulum stress-induced HRD1 and SEL1 expressions are mediated by IRE1-XBP1- and ATF6-dependent pathways, respectively PMID: 17967421
- overexpressed in the synovial cells of patients with rheumatoid arthritis, resulting in a state in which the cell deals with accumulated unfolded proteins excessively PMID: 18235538
- OS-9 and GRP94 deliver mutant alpha1-antitrypsin to the Hrd1-SEL1L ubiquitin ligase complex for ERAD PMID: 18264092
- These findings reveal a role for SEL1L and HRD1 in IgM quality control. PMID: 18314878
- proline-rich domain of HRD1 is necessary to promote the degradation of Pael-R and that the protein's transmembrane domain is necessary to transfer Pael-R from the endoplasmic reticulum (ER) to the cytosol. PMID: 18344614
- XTP3-B forms an endoplasmic reticulum quality control scaffold with the HRD1-SEL1L ubiquitin ligase complex and BiP PMID: 18502753
- analysed the promoter of human HRD1, which encodes an E3 ubiquitin ligase, an important component of ERAD PMID: 18664523
顯示更多
收起更多
-
亞細(xì)胞定位:Endoplasmic reticulum membrane; Multi-pass membrane protein.
-
蛋白家族:HRD1 family
-
組織特異性:Ubiquitously expressed, with highest levels in liver and kidney (at protein level). Up-regulated in synovial tissues from patients with rheumatoid arthritis (at protein level).
-
數(shù)據(jù)庫鏈接:
Most popular with customers
-
-
YWHAB Recombinant Monoclonal Antibody
Applications: ELISA, WB, IHC, IF, FC
Species Reactivity: Human, Mouse, Rat
-
Phospho-YAP1 (S127) Recombinant Monoclonal Antibody
Applications: ELISA, WB, IHC
Species Reactivity: Human
-
-
-
-
-